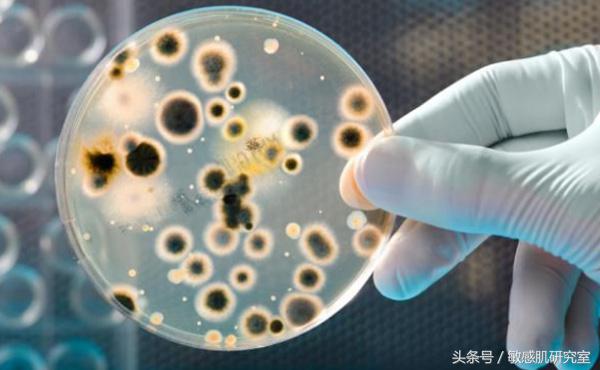

商场专柜一般都会提供试用装给顾客使用,大家在商场逛街的时候肯定也经常用专柜的试用装?有些人还觉得试用装有可能品质更好,试用的时候毫无顾忌地往皮肤上抹
试用装都是超级细菌培养皿
最近,韩国某机构在化妆品试用装中检测出各种细菌,最多甚至超过化妆品标准的2100倍
据韩联社1月9日报道,在这项调查中,16种唇部产品中,有4种检出存在1530-214万cfu/g的好氧性细菌,远远高于1000的标准值。有3种检出金黄色葡萄球菌。金黄色葡萄球菌则会引发皮肤疾病、呕吐、腹泻、腹痛、恶心等感染症状。
16种眼影中2种检出510-2300cfu/g的好氧性细菌,高于500的标准值。有1种检出存在金黄色葡萄球菌。10种睫毛膏中,5种检出500-2200 cfu/g的好氧性细菌,同样高于500的标准值。

试用装一般开盖时间长、而且容易交叉污染,极易引发皮肤问题
韩国消费者院表示,眼影、睫毛膏、口红等化妆品大部分是需要打开盖子使用的,相对于管状、挤压类的化妆品更容易被交叉污染。如果在眼睛、唇部等敏感部位使用可能会引起皮肤疾病或炎症。
事实上,大部分试用装都是没有盖子直接敞开的状态,也没有标注开封日期。16个接受调查的化妆品卖场中,13家店的眼影、9家店的口红都没有盖子。42种被调查的化妆品中,仅6种标注着开封日期。
使用被细菌、真菌污染的化妆品可能引起皮肤疾病,如果接触伤口或免疫力降低还可能引发炎症
室长注:前几天在丝芙兰试娇韵诗、兰蔻,和之前用的味道不一样,现在想起来,应该是开盖太长时间,早就变质了;还有还有只能保存7天的倩碧维C粉都已经完全氧化成了黄褐色……
以后使用产品真的要谨慎,尤其是敏感肌,而且要多用手试少用脸试
版权声明:CosMeDna所有作品(图文、音视频)均由用户自行上传分享,仅供网友学习交流。若您的权利被侵害,请联系删除!
本文链接://www.cosmedna.com/article/895588694.html







